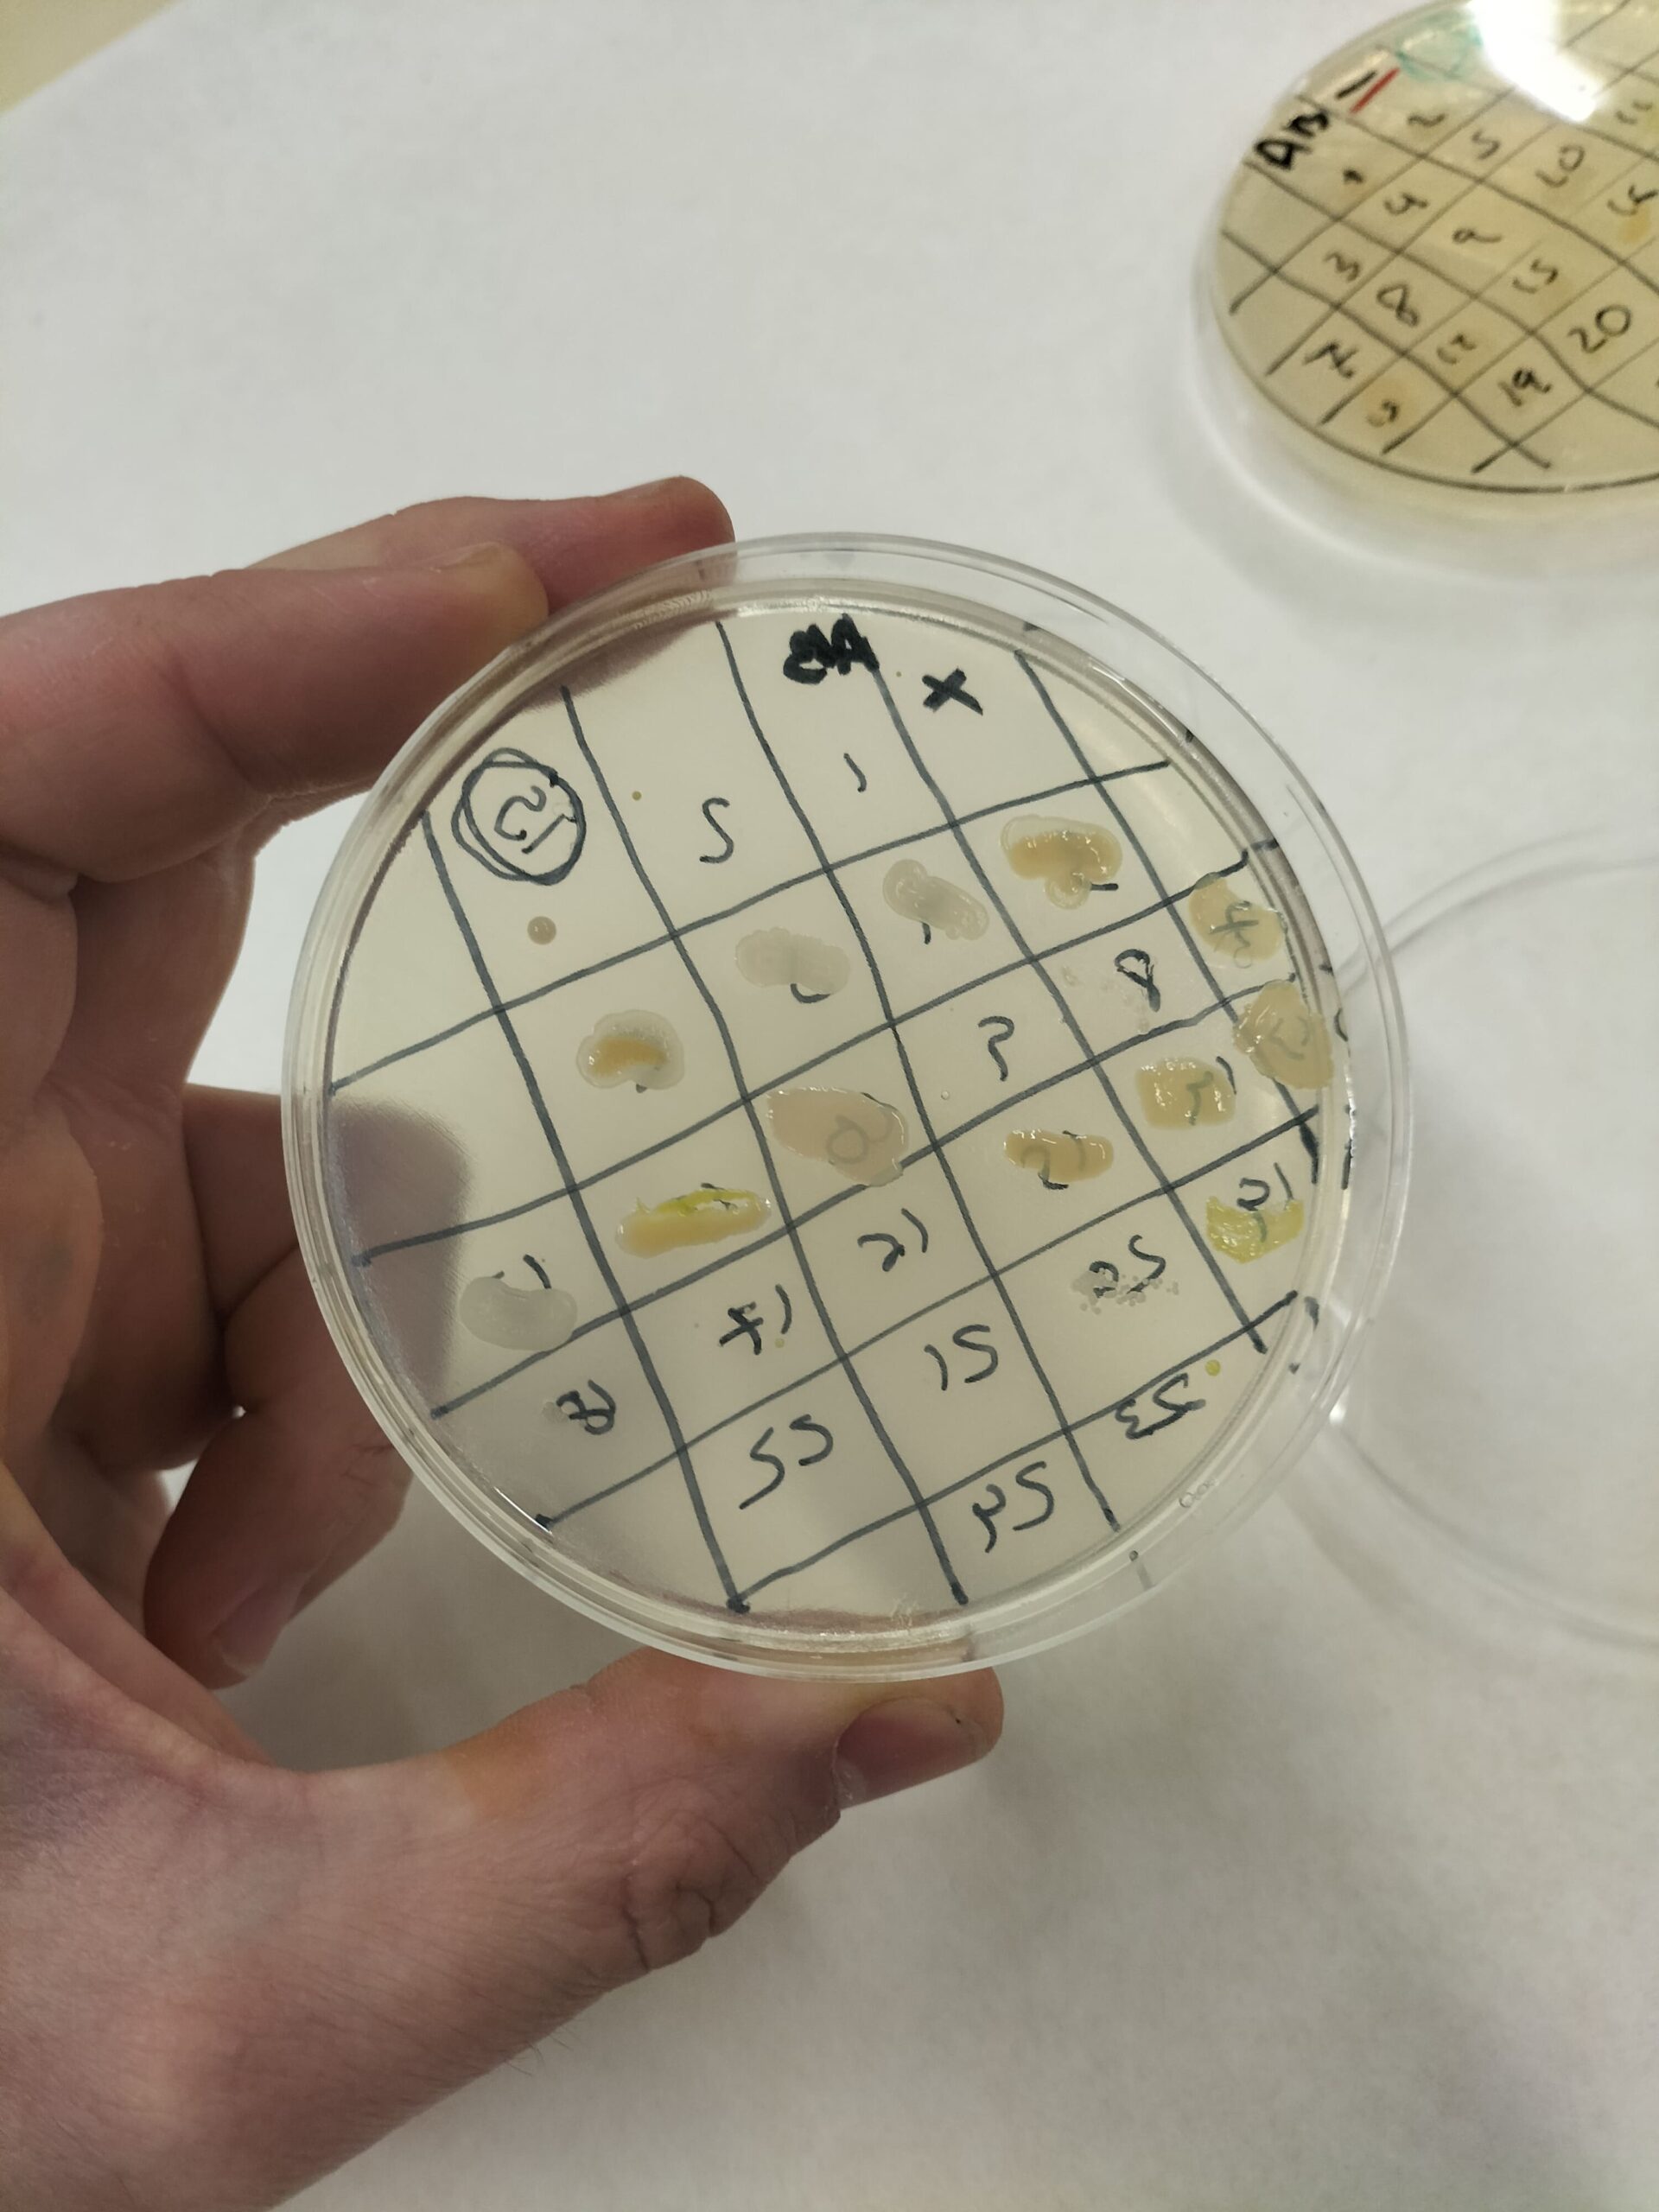

Durant les darreres setmanes, l’alumnat de 4t d’ESO hem estat participant en el projecte @micromonuab fent recerca sobre nous antibiòtics per combatre les restistències dels bacteris. Han estat unes sessions de laboratori en les que hem col·laborat amb investigadors i estudiants de microbiologia, biotecnologia i biomedicina de la UAB i l’Hospital de Sant Pau.
Durant les darreres setmanes, l’alumnat de 4t d’ESO hem estat participant en el projecte @micromonuab fent recerca sobre nous antibiòtics per combatre les restistències dels bacteris. Han estat unes sessions de laboratori en les que hem col·laborat amb investigadors i estudiants de microbiologia, biotecnologia i biomedicina de la UAB i l’Hospital de Sant Pau.
 Hem après moltíssim sobre bacteris, cultius, antibiòtics, creixement bacterià… i ara tenim moltes idees a explicar-vos!
Hem après moltíssim sobre bacteris, cultius, antibiòtics, creixement bacterià… i ara tenim moltes idees a explicar-vos!
 Estigueu atents que segurament tindreu notícies nostres aviat per explicar-vos tot el que hem après!
Estigueu atents que segurament tindreu notícies nostres aviat per explicar-vos tot el que hem après!